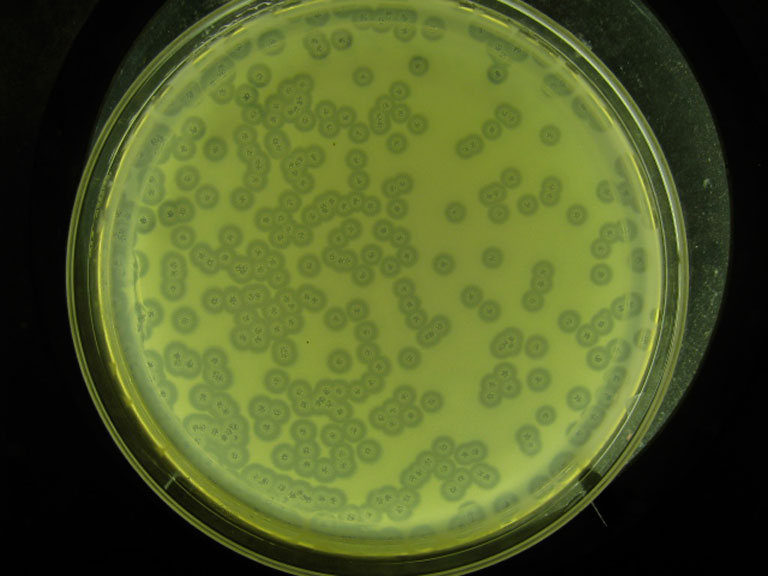

Virus Strain Isolated from the Charles River
Virus Strain Isolated from the Charles River
Submitted by Mandana Sassanfar of the Department of Biology
MIT Department of Biology
Mandana Sassanfar
Department of Biology
Photograph
"This virus strain that was isolated from the Charles river is able to grow on a lawn of Pseudomonas Aeruginosa.
My goal is to expose MIT freshmen to what basic research is like by choosing a very simple model system (bacteria and their phages) and teach them various technical skills routinely used in molecular biology. Each student must identify a strain of bacteria that was isolated from the Charles river and attempt to isolate and characterize a phage that grows on the bacteria."